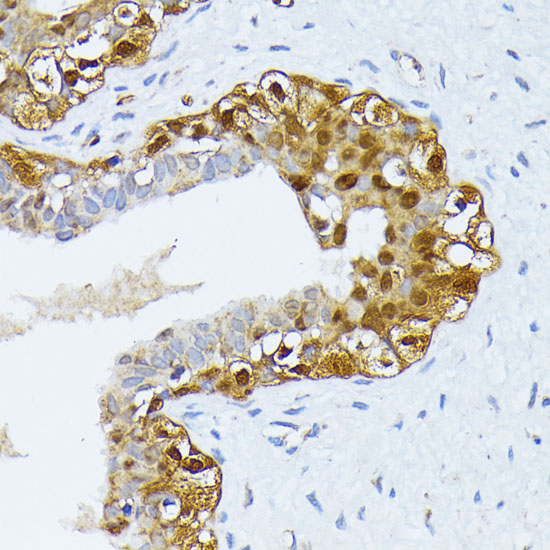
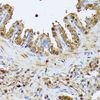

SMN1 Rabbit Polyclonal Antibody
Other products for "SMN1"
Specifications
| Product Data | |
| Applications | IHC, WB |
| Recommended Dilution | WB,1:500 - 1:2000 IHC,1:50 - 1:200 |
| Reactivities | Human, Mouse, Rat |
| Modifications | Unmodified |
| Host | Rabbit |
| Isotype | IgG |
| Clonality | Polyclonal |
| Immunogen | Recombinant fusion protein containing a sequence corresponding to amino acids 80-150 of human SMN1 (NP_000335.1). |
| Formulation | Buffer: PBS with 0.02% sodium azide,50% glycerol,pH7.3. |
| Concentration | lot specific |
| Purification | Affinity purification |
| Conjugation | Unconjugated |
| Storage | Store at -20℃. Avoid freeze / thaw cycles. |
| Stability | Shelf life: one year from despatch. |
| Predicted Protein Size | 27kDa/28kDa/30kDa/31kDa |
| Gene Name | survival of motor neuron 1, telomeric |
| Database Link | |
| Background | This gene is part of a 500 kb inverted duplication on chromosome 5q13. The repetitiveness and complexity of the sequence have also caused difficulty in determining the organization of this genomic region. The telomeric and centromeric copies of this gene are nearly identical and encode the same protein. However, mutations in this gene, the telomeric copy, are associated with spinal muscular atrophy; mutations in the centromeric copy do not lead to disease. The centromeric copy may be a modifier of disease caused by mutation in the telomeric copy. The critical sequence difference between the two genes is a single nucleotide in exon 7, which is thought to be an exon splice enhancer. Note that the nine exons of both the telomeric and centromeric copies are designated historically as exon 1, 2a, 2b, and 3-8. The protein encoded by this gene localizes to both the cytoplasm and the nucleus. Within the nucleus, the protein localizes to subnuclear bodies called gems which are found near coiled bodies containing high concentrations of small ribonucleoproteins (snRNPs). This protein forms heteromeric complexes with proteins such as SIP1 and GEMIN4, and also interacts with several proteins known to be involved in the biogenesis of snRNPs, such as hnRNP U protein and the small nucleolar RNA binding protein. Multiple transcript variants encoding distinct isoforms have been described. |
| Synonyms | BCD541; Gemin-1; SMA; SMA1; SMA2; SMA3; SMA4; SMA@; SMN; SMNC; SMNT; T-BCD541 |
| Reference Data | |
Documents
| Product Manuals |
| FAQs |
| SDS |
{0} Product Review(s)
0 Product Review(s)
Submit review
Be the first one to submit a review
Product Citations
*Delivery time may vary from web posted schedule. Occasional delays may occur due to unforeseen
complexities in the preparation of your product. International customers may expect an additional 1-2 weeks
in shipping.






























































































































































































































































 Germany
Germany
 Japan
Japan
 United Kingdom
United Kingdom
 China
China